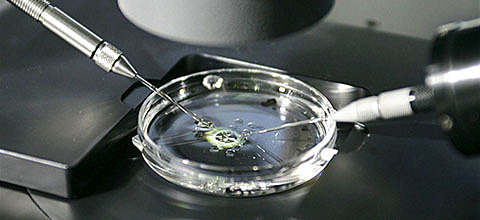
Nuevas formas de concepción

Principales corrientes teóricas que permiten comprender el desarrollo infantil.
-
Dos corrientes de pensamiento mencionan a las teorías Aristotélicas: los animalculistas que creían que los animálculos o espermatozoides eran pequeñas personitas alojados en la cabeza del espermatozoide que crecían en un ambiente de nutrición,y los ovistas que creían que los ovarios eran seres diminutos ya formados cuyo crecimiento se daba con el espermatozoide del varón.
-
Dietrich Tiedmann, publica el diario del bebé que refiere a las primeras anotaciones sobre el desarrollo sensorial,motor,de lenguaje y cognitivo de su hijo y cuyo error fue concluir que el chupeteo era adquirido no instintivo.
-
Aparece en Francia, Aveyron,un niño que se creía salvaje,dando evidencia del impacto relativo de la naturaleza y la crianza,en una época donde se reemplaza la especulación metafísica por la nueva perspectiva científica.
-
Margareth Mead,realiza trabajo de campo en pueblos poco civilizados observando las diferentes familias y culturas y determinando que el temperamento varía de una a otra y que la cultura define el rol masculino o femenino.
-
Los científicos descentralizan el misterio de la concepción como en el caso del niño salvaje de Aveyron,y es a partir de esto que se enseña a la gente a comprenderse a sí misma y a conocer ¿qué había influenciado durante su infancia?
-
Antecesora de la actual "revolución cognitiva",el desarrollo es producto del esfuerzo de los niños por comprender su mundo y actuar sobre él como una capacidad innata.
Sus etapas son: Sensoriomotora,preoperacional,operaciones concretas,operaciones formales.
Son tres sus procesos: organización,adaptación,equilibración. -
B.F. Skinner encontró que un organismo tiende a repetir una conducta reforzada por consecuencia deseable inhibiendo una respuesta que haya sido castigada.(reforzamiento o castigo = modificación de la conducta)
-
Teoría conocida como "crisis de identidad" que indica que las personas necesitan confiar y desconfiar para protegerse a sí mismo del peligro.Estas son: Confianza vs desconfianza;Autonomía,vergüenza - duda; iniciativa- culpa;iniciativa vs inferioridad;identidad vs confusión de identidad; intimidad-aislamiento; generatividad vs estancamiento;integridad vs desesperación.
-
Freud creía que los orígenes de las alteraciones emocionales provienen de las experiencias reprimidas de la infancia.
Propone tres instancias hipotéticas de la personalidad: " el eyo,el yo y el súper yo" así como las 5 etapas del desarrollo psicosocial: "oral,anal,fálica,latencia y genital". -
Concibe el crecimiento cognitivo como un proceso en conjunto por medio de la interacción social.Desarrolla el término ZDP o zona de desarrollo próximo.(diferencia entre lo que el niño hace por sí mismo y lo que puede hacer con ayuda).
-
El desarrollo del niño depende del contexto en el que se desenvuelve,que engloban patrones históricos y culturales que afectan su vida en la sociedad,como el rendimiento académico y la conducta antisocial.La teoría se basa en cinco sistemas contextuales interconectados: microsistema,mesosistema,exosistema,macrosistema( incluye valores morales y sistemas sociales) ,cronosistema
-
Se da énfasis en que los procesos cognitivos se dan por observación de modelos,que se transforman en patrones más complejos desarrollando el sentido de la "autoeficacia"
-
Factores biológicos y psicológicos ,sociales económicos y culturales ayudan a moldear la posibilidad de un desarrollo óptimo.Aparecen los términos de : rango de reacción,canalización,interacción genotipo-ambiente,selección de nicho que definen la colaboración entre herencia y el ambiente.
-
Fertilización in vitro (FIV)reproducción asistida,aumenta los nacimientos múltiples y prematuros,así como la maduración in vitro (MIV).su uso puede aumentar el riesgo de anormalidades cromosómicas y pérdida fetal,aunque estudios determinan que el desarrollo socioemocional de niños entre los 12 años, no difiere de los niños concebidos de forma natural o adoptados.
Want to make a timeline like this?
Use Timetoast to turn dates, events, milestones, and phases into a clear visual timeline you can build and share. Timetoast is a timeline maker for work, school, research, and stories.